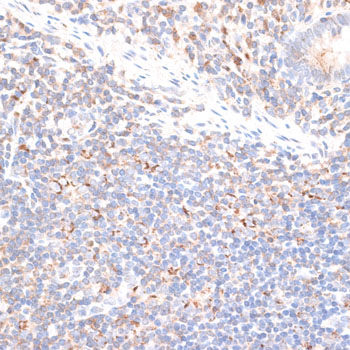
Immunohistochemistry - KIF14 Polyclonal Antibody

-
Product Name
KIF14 Polyclonal Antibody
- Documents
-
Description
Polyclonal antibody to KIF14
-
Tested applications
WB, IHC, IF
-
Species reactivity
Human, Mouse, Rat
-
Alternative names
KIF14 antibody; MKS12 antibody; kinesin family member 14 antibody
-
Isotype
Rabbit IgG
-
Preparation
Antigen: Recombinant fusion protein containing a sequence corresponding to amino acids 1399-1648 of human KIF14 (NP_055690.1).
-
Clonality
Polyclonal
-
Formulation
PBS with 0.02% sodium azide, 50% glycerol, pH7.3.
-
Storage instructions
Store at -20℃. Avoid freeze / thaw cycles.
-
Applications
WB 1:1000 - 1:2000
IHC 1:50 - 1:200
IF 1:50 - 1:200 -
Validations

Western blot - KIF14 Polyclonal Antibody
Western blot analysis of extracts of various cell lines, using KIF14 antibody at 1:1000 dilution.Secondary antibody: HRP Goat Anti-Rabbit IgG (H+L) at 1:10000 dilution.Lysates/proteins: 25ug per lane.Blocking buffer: 3% nonfat dry milk in TBST.Detection: ECL Basic Kit .Exposure time: 15s.

Immunohistochemistry - KIF14 Polyclonal Antibody
Immunohistochemistry of paraffin-embedded rat ovary using KIF14 antibody at dilution of 1:100 (40x lens).

Immunohistochemistry - KIF14 Polyclonal Antibody
Immunohistochemistry of paraffin-embedded rat heart using KIF14 antibody at dilution of 1:100 (40x lens).

Immunohistochemistry - KIF14 Polyclonal Antibody
Immunohistochemistry of paraffin-embedded human colon carcinoma using KIF14 antibody at dilution of 1:100 (40x lens).
Immunohistochemistry - KIF14 Polyclonal Antibody
Immunohistochemistry of paraffin-embedded human appendix using KIF14 antibody at dilution of 1:100 (40x lens).

Immunohistochemistry - KIF14 Polyclonal Antibody
Immunohistochemistry of paraffin-embedded human mammary cancer using KIF14 antibody at dilution of 1:100 (40x lens).

Immunohistochemistry - KIF14 Polyclonal Antibody
Immunohistochemistry of paraffin-embedded human stomach using KIF14 antibody at dilution of 1:100 (40x lens).
-
Background
Microtubule motor protein that binds to microtubules with high affinity through each tubulin heterodimer and has an ATPase activity (By similarity). Plays a role in many processes like cell division, cytokinesis and also in cell proliferation and apoptosis. During cytokinesis, targets to central spindle and midbody through its interaction with PRC1 and CIT respectively. Regulates cell growth through regulation of cell cycle progression and cytokinesis. During cell cycle progression acts through SCF-dependent proteasomal ubiquitin-dependent protein catabolic process which controls CDKN1B degradation, resulting in positive regulation of cyclins, including CCNE1, CCND1 and CCNB1. During late neurogenesis, regulates the cerebellar, cerebral cortex and olfactory bulb development through regulation of apoptosis, cell proliferation and cell division (By similarity). Also is required for chromosome congression and alignment during mitotic cell cycle process. Regulates cell spreading, focal adhesion dynamics, and cell migration through its interaction with RADIL resulting in regulation of RAP1A-mediated inside-out integrin activation by tethering RADIL on microtubules.
Related Products / Services
Please note: All products are "FOR RESEARCH USE ONLY AND ARE NOT INTENDED FOR DIAGNOSTIC OR THERAPEUTIC USE"
